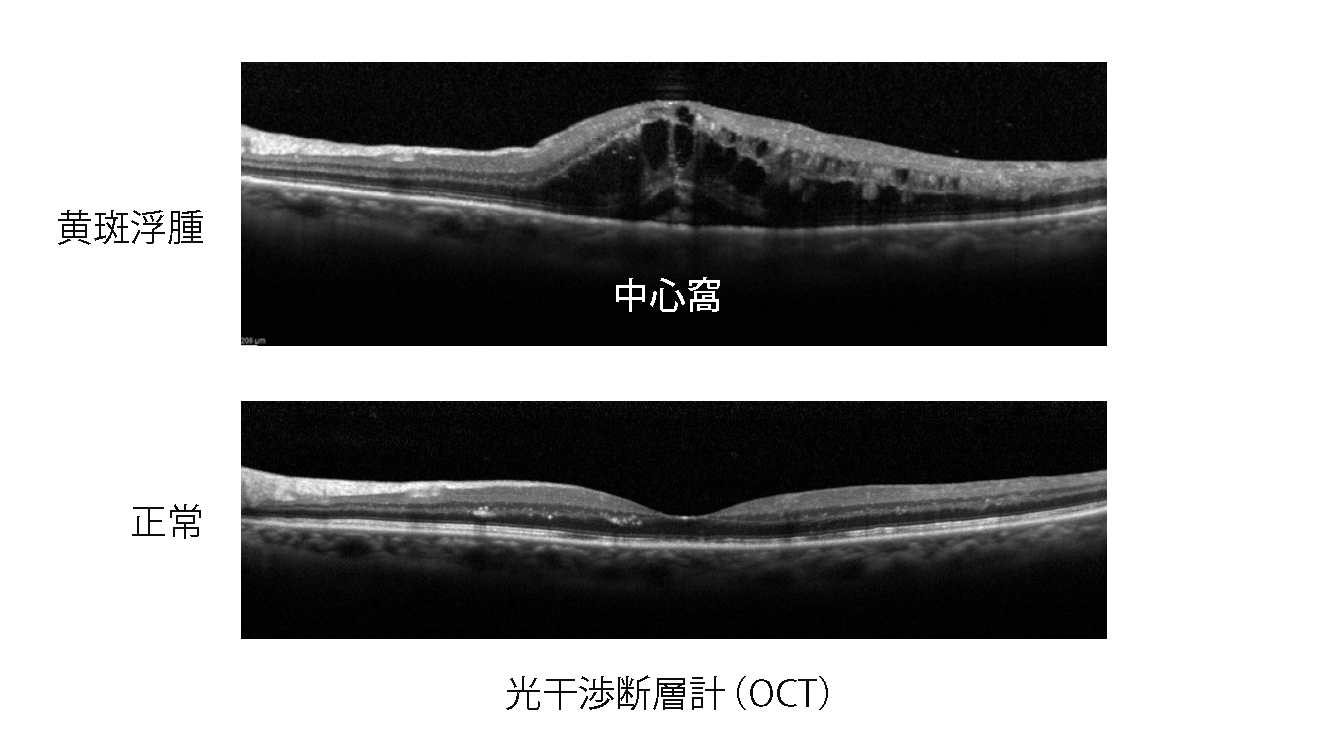

網膜静脈閉塞症と診断されたら
京都大学大学院医学研究科 眼科学教授 辻川明孝
網膜静脈閉塞症という病気をご存じの方は多くないでしょう。
網膜静脈閉塞症は、網膜の太い静脈が詰まって、血流が停滞することによって発症します。充分な血液が流れなくなると、網膜は正常に機能しなくなり、視界がぼやけたり、視力が低下するなどの症状を引き起こします。
基本的には 60 歳以降の高齢の方に起こる病気で、高血圧、糖尿病、高脂血症などの全身疾患がリスクファクターになります。
また、遠視、緑内障などの眼の病気のある人に、発症しやすくなります。
病名には馴染みがなくとも、高齢者にはよく見られる眼の病気です。この小冊子で、網膜静脈閉塞症について理解し、積極的に治療を受けましょう。
京都大学大学院医学研究科 眼科学教授
辻川明孝
眼はよくカメラに例えられます。カメラのフィルムにあたる部分が網膜です。瞳孔から入ってきた光は網膜で捉えられ、脳に伝わります。しかし、フィルムと違って、網膜は均一な構造をしているわけではありません。
網膜の中央を黄斑と呼び、黄斑の中心を中心窩呼びます。周辺部の網膜に比べて、中心窩の感度は際だって高くなっています。中心窩の機能が正常だと、1.0 の視力も得られますが、中心窩が傷つくと視力は極端に低下してしまいます。
このような中心窩の障害による視力低下は、メガネやコンタクトレンズでは矯正できません。


網膜が正常に機能するためには血液を介して、充分な栄養と酸素の供給が必要です。
網膜中心動脈から眼内に供給された血液は、網膜の中を循環したあと、網膜中心静脈になって流れ出します。
網膜は厚さ 200 〜 300 マイクロメートルの薄い構造をしています。網膜内では、枝分かれした毛細血管は網目の様に広がって、網膜に栄養と酸素を供給しています。
網膜の血管にはバリアがあるため、通常は血管から血液は漏れ出さない構造になっています。

中枢神経である網膜は脳の一部です。したがって、いったん細胞が死んでしまうと、よみがえることはありません。
脳梗塞は、脳に血液を送り込む動脈が詰まる病気です。充分な血液が届かなくなると、脳細胞は短時間で死滅してしまい、その部分の脳が担っている機能を失います。
同じように、網膜にも、動脈の流れが悪くなる網膜動脈閉塞症という病気が存在し、発症すると、急に見えにくくなります。
一方、ここでお話しする網膜静脈閉塞症は、網膜から流れ出す血液が通る静脈が詰まって、血液の流れが悪くなる病気です。

静脈の流れが悪くなると、網膜の細胞に充分な栄養や酸素が届けられなくなり(虚血)、網膜の機能が低下します。このような虚血状態が続くと、徐々に網膜の細胞は死んでいきます。
虚血に陥った細胞は、VEGF(血管内皮増殖因子)というサイトカイン(指令を伝える分子)を放出し、病態をいっそう悪化させます。更に、静脈の流れが悪くなると、行き場を失った網膜内の血液が毛細血管から漏れ出し、網膜出血になります。
また、血漿成分が網膜内に漏れ出すことによって、黄斑がむくんだ状態(黄斑浮腫)になり、視力も低下します。
網膜静脈閉塞症は網膜中心静脈閉塞症と網膜静脈分枝閉塞症に分けられます。(下図)
網膜内の比較的太い静脈の血流障害によって生じるのが、網膜静脈分枝閉塞症(図 2)です。
また、網膜から流れ出す静脈が最後に一本にまとまった、網膜中心静脈の血流障害で生じるのが、網膜中心静脈閉塞症(図 1)です。
広い範囲の網膜が障害される網膜中心静脈閉塞症の方が、視機能に与える影響は大きくなります。
しかし発症の頻度は、網膜静脈分枝閉塞症の方が5倍程高くなります。

症状は血液の流れが悪くなった網膜の場所によります。
・血液の流れが悪くなった領域では、網膜の機能が低下するため、視界の一部や全体がぼやけます。
・障害が中心窩に及ぶと、視力も低下します。
・黄斑浮腫が中心窩に及ぶと、視力低下、小視症(モノが小さく見える)、変視症(ゆがんで見える)などの症状を伴います。
しかし、周辺部の網膜だけで血流が悪くなった場合には、自覚症状が現れないこともよくあります。発症から数年してから起こる硝子体出血によって、視界のかすみを自覚することもあります。

・まず、視力・眼圧などの一般的な検査を行います。
・その後、瞳を開いて(散瞳)、隅々まで眼底検査を行って、診断します。
・黄斑浮腫の有無を把握するために光干渉断層計(OCT)検査を行います。
・更に、毛細血管の詰まっている程度を評価するためにフルオレセイン蛍光眼底造影検査を行うこともあります。
・最近は、造影剤を用いない OCT アンジオグラフィー(OCTA)検査で、毛細血管の詰まっている程度を評価することもあります。

網膜静脈閉塞症には様々な合併症が生じ、視力低下の原因となります。
黄斑浮腫:発症からまもない急性期には、血管から漏れ出した血漿成分が黄斑部に貯留すると、黄斑浮腫を形成します。
眼圧の上昇:網膜中心静脈閉塞症では、血管新生緑内障によって眼圧が上昇することがあります。
硝子体出血:発症から時間が経過した慢性期には、網膜新生血管から硝子体出血を生じることがあります。
網膜剥離:また、まれに網膜に穴が開いて、網膜剥離に至ることがあります。

黄斑浮腫は、網膜静脈閉塞症の一番重要な合併症です。血管から漏れ出した血漿成分が黄斑部にたまると、網膜がむくんで黄斑浮腫を形成します。また、虚血になった網膜が産生するサイトカイン(VEGF)は、血管からの血漿の漏れを促進するので、更に、黄斑浮腫は悪くなっていきます。
黄斑浮腫は中心窩に及ぶことが多く、中心窩に及ぶと視力は低下します。
黄斑浮腫は自然に治ることもありますが、最近は、積極的に治療を行うことが多くなってきました。しかし、いったん症状が生じると、見え方が完全に元に戻ることは少ないでしょう。

現在、黄斑浮腫に対しては、抗VEGF薬の硝子体注射が第1選択の治療になっています。
虚血網膜から産生されるサイトカインである VEGF の働きをブロックする薬剤を眼の中に注射します。目薬の麻酔を行いますので、ほとんど痛みはありません。
効果は数日で現れますが、注射から数ヶ月で再発することが多いので、再発しなくなるまで何度か注射を必要とします。
それ以外にも、硝子体手術、レーザー光凝固術、ステロイドの注射などを行うこともあります。

網膜静脈の血液の流れが悪くなると、しばしば、その領域の毛細血管が詰まってしまいます。(下図)
広い範囲の毛細血管に血液が流れなくなると、虚血網膜から産生されるサイトカイン(VEGF)により、網膜上に新しい血管(網膜新生血管)が発生することがあります。
網膜新生血管に対して硝子体の牽引がかかると眼内に出血(硝子体出血)が生じます。
硝子体出血は慢性期の合併症ですので、網膜静脈閉塞症が生じてから数年後に発症することが多いでしょう。

広範囲の網膜の毛細血管が詰まっている場合(虚血型)には、虚血網膜からの VEGF 産生を抑えるために、予防的にレーザー光凝固術を行います。
また、すでに網膜新生血管が生じている場合にも、新生血管を退縮させる目的で、レーザー光凝固術を行います。
新生血管から硝子体出血がすでに発症し、充分にレーザー光凝固術を行うことが難しい場合には、硝子体手術によって出血を除去した上で、レーザー光凝固術を行います。

網膜中心静脈閉塞症において、広い虚血網膜を伴っている場合、産生されたサイトカイン(VEGF)によって、虹彩・隅角に新生血管が生じることがあります。
この隅角新生血管は、隅角を閉塞させ、眼圧を上昇させることがあります。この状態を血管新生緑内障とよび、治りにくいタイプの緑内障です。
網膜静脈分枝閉塞症では通常、血管新生緑内障に至ることはまれです。

網膜中心静脈閉塞症において、広い虚血網膜を伴っている場合、血管新生緑内障を予防するために、広く網膜にレーザー光凝固術を行います。
・すでに血管新生緑内障が発症し、眼圧が上昇している場合には、抗VEGF薬の硝子体注射を行い、その上で、広く網膜にレーザー光凝固術を行います。
・それでも眼圧のコントロールができない場合は、眼圧を下げるために点眼薬、内服薬の処方を行います。
・点眼薬や内服薬でも眼圧がコントロールできない場合には、緑内障手術を行います。

【関連記事もご覧ください】
目についての健康情報
- 40歳からはじめたい アイフレイル(目の老化)対策――健康寿命をのばすために
- 40歳を過ぎたら受けよう!!眼底検査 目の健康を守るために
- 防ごう目のトラブル!!コンタクトレンズの眼合併症
- 網膜静脈閉塞症と診断されたら
- 糖尿病網膜症による視力低下―予防と治療― ~運転免許証や仕事を失わないために~
- ぶどう膜炎 なぜ? どうしたらいいの
- 流涙症で困っている方へ
- 気をつけよう!子どもの近視
- 緑内障といわれた方へ―日常生活と心構え―
- 40 歳を過ぎたなら知っておきたい黄斑前膜―診断と治療―
- 眼瞼下垂に悩むかたへ
- 白内障手術と眼内レンズ 眼内レンズを上手に選ぶために
- ドライアイに悩む方へ―生活の注意と治療の目安―
- 知っておきたい加齢黄斑変性―治療と予防―
- 色覚異常といわれたら
- よくわかる緑内障―診断と治療―
- 白内障手術を受ける方へ 知っておきたい白内障術後のケア
- 中高年からのロービジョンケア
- コンタクトレンズと目のお化粧—健康で美しい目を守るには—
- 子どもの目と外傷
- 子どものコンタクトレンズQ&A
- 目の定期検査のすすめ
- パソコンと目
- メガネのかしこい使い方
- 子供が近視といわれたら
- 飛蚊症と網膜剥離 なぜ?どうするの
- 40代で始まる目の老化
- 糖尿病で失明しないために
- コンタクトレンズと感染症
- アレルギー性結膜炎の治療と対策
- 子どもの目の心身症 -心因性視力障害-
- 高血圧性網膜症
- 子どもの弱視・斜視
- 子どもの遠視
- アトピー性皮膚炎と目
- ウイルス性結膜炎
- 屈折異常と眼精疲労
- 花粉症と目
- 遺伝性の目の病気
- ぶどう膜炎
- 白内障と手術
- 赤ちゃんの目の病気
- 黒いものが飛ぶ 飛蚊症
- 角膜の病気





